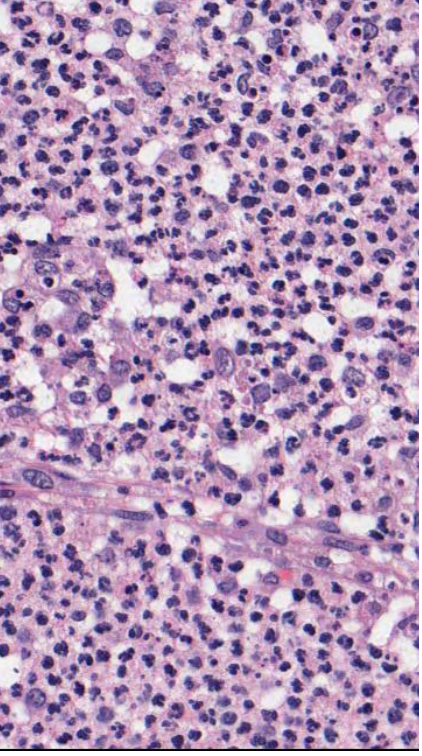
<p>what type of cells do you see?</p>
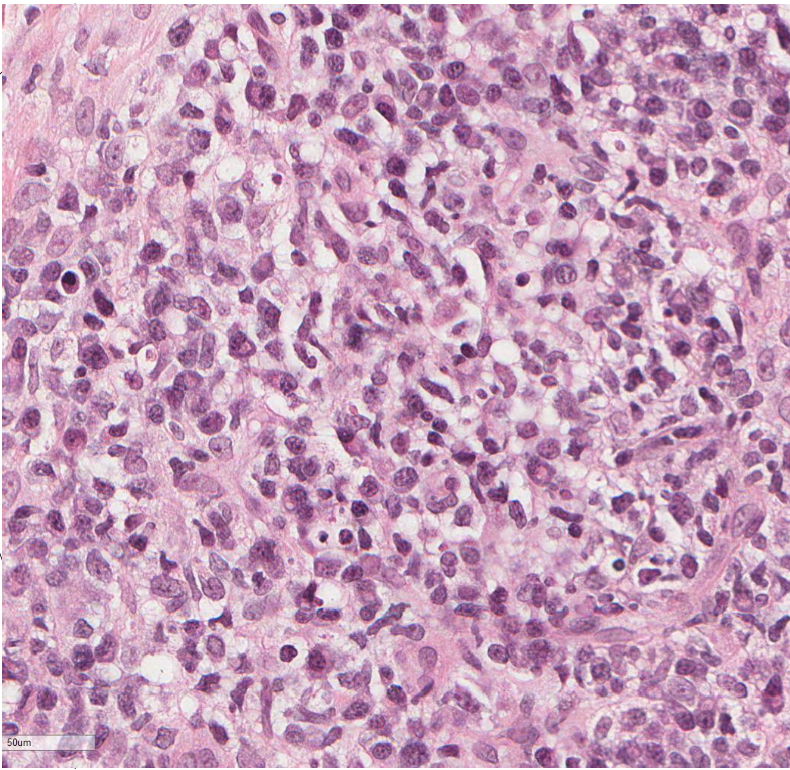
<p>what cells do you see?</p>
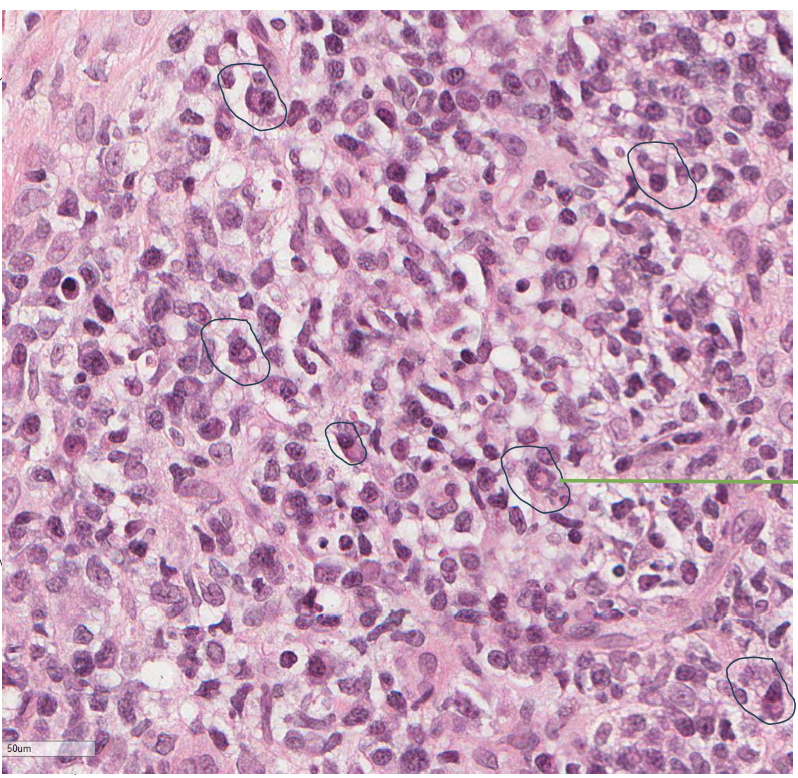
<p>plasma cells! = chronic inflammation </p>

Histology - Acute vs. Chronic Inflammation
1/12
There's no tags or description
Looks like no tags are added yet.
Name | Mastery | Learn | Test | Matching | Spaced |
|---|
No study sessions yet.
13 Terms

what should you look at first when determining cell injury?
dermal epidermal junction

does the dermal-epidermal junction look intact?
YES
what type of cells do you see?
neutrophils!
messy appearance of cells
nucleus of many cells have multi-lobed appearance
when you see neutrophils, what type of inflammatory response is happening?
acute inflammation

normal or abnormal? localized or diffuse?
abnormal, diffuse

Is the dermal/epidermal junction intact?
NO! Full thickness loss of epidermis, definition of an ulcer


what cells do you see?
this means acute inflammation!


is this abnormal or normal? localized or diffuse?
diffused! abnormal

does the dermal/epidermal junction intact?
YES
what cells do you see?
plasma cells! = chronic inflammation

what abnormal process is happening here?
necrosis

name the biological process shown in this image
acute inflammation
neutrophils !!

name the biological process shown in this image
chronic inflammation
lymphocytes